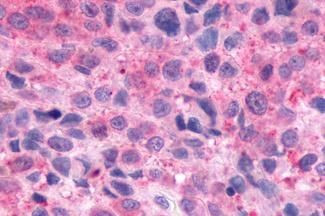
Opsin 3 Antibody in Immunohistochemistry (Paraffin) (IHC (P))

Search
Invitrogen
Opsin 3 Polyclonal Antibody
{{$productOrderCtrl.translations['antibody.pdp.commerceCard.promotion.promotions']}}
{{$productOrderCtrl.translations['antibody.pdp.commerceCard.promotion.viewpromo']}}
{{$productOrderCtrl.translations['antibody.pdp.commerceCard.promotion.promocode']}}: {{promo.promoCode}} {{promo.promoTitle}} {{promo.promoDescription}}. {{$productOrderCtrl.translations['antibody.pdp.commerceCard.promotion.learnmore']}}




Please note: We are reviewing Western blot images included in the antibody testing data in our catalog, including those provided by third parties. Unless expressly labeled or annotated as “raw-unedited”, Western blot images included in the antibody testing data in our catalog may have been edited, optimized or otherwise adjusted for presentation.
产品信息
PA1-32531
种属反应
宿主/亚型
分类
类型
抗原
偶联物
形式
浓度
规格
纯化类型
保存液
内含物
保存条件
运输条件
RRID
产品详细信息
PA1-32531 detects Encephalopsin from human samples.
靶标信息
Opsins are members of the guanine nucleotide-binding protein (G protein)-coupled receptor superfamily. In addition to the visual opsins, mammals possess several photoreceptive non-visual opsins that are expressed in extraocular tissues. This gene, opsin 3, is strongly expressed in brain and testis and weakly expressed in liver, placenta, heart, lung, skeletal muscle, kidney, and pancreas. The gene may also be expressed in the retina. The protein has the canonical features of a photoreceptive opsin protein. May play a role in encephalic photoreception. Strongly expressed in brain. Highly expressed in the preoptic area and paraventricular nucleus of the hypothalamus. Shows highly patterned expression in other regions of the brain, being enriched in selected regions of the cerebral cortex, cerebellar Purkinje cells, a subset of striatal neurons, selected thalamic nuclei, and a subset of interneurons in the ventral horn of the spinal cord.
仅用于科研。不用于诊断过程。未经明确授权不得转售。